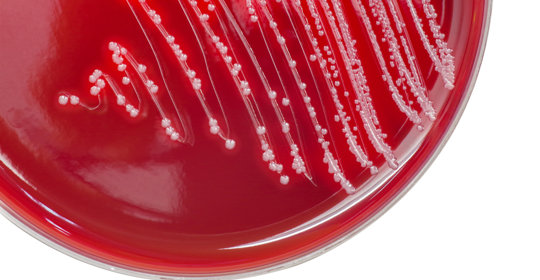

老人咳嗽就吐可能與咽喉部炎症、胃食管反流、咳嗽變異性哮喘、腦血管疾病等因素有關。建議及時就醫,明確原因後,在醫生的指導下採取相應的處理措施。

老人咳嗽一天都沒好可能與呼吸道疾病、飲食不當、用藥不當、不良生活習慣等因素有關,建議根據發病時的臨床症狀、既往病史以及相關檢查結果,明確診斷後進行治療,可透過一般治療、藥物治療等緩解症狀。

老人出現腸阻塞,主要的治療方法有禁食水、胃腸減壓、灌腸、藥物治療、手術治療等,具體治療效果與病情嚴重程度、個人體質等有關,因人而異,但一般都比較好治療。建議老人及時到醫院就診,在醫生的指導下選擇合適的治療方法。

老人出現腸阻塞,可以透過禁食水、胃腸減壓、灌腸、藥物治療,以及手術治療等方式治療,一般治療效果比較好。建議老人在醫生的指導下,根據自身情況選擇合適的治療方式。

老人出現腸阻塞,可以透過禁食水、胃腸減壓、灌腸、藥物治療,以及手術治療等方式來進行治療。若治療及時,一般治療效果較好。建議老人在醫生的指導下進行治療,以免貽誤病情。

老人咳出來的痰有血,在臨床上比較常見,可能是由支氣管疾病、肺部疾病、心血管疾病、免疫系統疾病引起的。若伴有其他不適,建議及時就醫,根據具體的症狀以及誘因進行針對性治療。

老人腳發黑,開始腐爛,長蟲子,一般多考慮為足癬,是一種常見的真菌感染性皮膚病,易發生在腳趾間、腳底、腳背等部位。可透過日常護理、區域性用藥、口服藥物等方法治療,建議及早就醫,遵醫囑用藥。

80歲老人肚子脹氣,可能與消化不良、慢性胃炎、胃潰瘍、腸阻塞等因素有關。需要根據具體原因在醫生指導下進行針對性治療,如服用藥物、進行按摩、調整飲食、手術治療。
老人血小板過高可能與生理因素或病理因素有關,生理因素通常不需要治療,病理因素如原發性血小板增多症、慢性粒細胞白血病、急性感染、急性溶血、惡性腫瘤等,要根據具體情況進行治療。

80多歲老人子宮脫垂,若無明顯不適症狀,一般不需要治療。若出現伴隨症狀,則需要透過一般治療、物理治療、藥物治療,以及手術治療等方式進行改善。

老人血壓不穩定,可以是生理性因素所致,也可能是病理性因素所致,生理性因素主要包括遺傳、年齡等,病理性因素主要包括高血壓、冠心病、糖尿病、高脂血症等。建議及時就醫,明確具體原因。

老人出現腸脹氣,可能是飲食不當、功能性消化不良、腸阻塞、胃潰瘍等原因導致。建議及時到醫院透過檢查明確具體原因,然後根據醫生建議進行針對性治療。

老人舌頭腫大,考慮與外傷、舌炎、舌頭囊腫、舌下腺囊腫、口腔潰瘍、腫瘤等因素有關。建議及時就醫,明確具體原因後,在醫生指導下進行針對性治療。

高齡老人血壓過低,可能會出現頭暈、乏力等症狀,此時有一定的危險,可以透過飲食調理、生活調理、適當運動、使用藥物等方法進行治療。建議高齡老人及時到醫院就診,在醫生指導下給予相應的治療。

本文介紹了84歲老人不想吃飯的原因。這種情況可能是生理性的,如年齡增加、體力活動減少及心情影響;也可能是病理性的,如胃部疾病、感染性疾病、慢性腎臟疾病、心臟衰竭、惡性腫瘤等。針對老年人群,若出現長時間食慾不振或其他身體異常表現,應及時就醫並完善相關檢查,以便於早期發現潛在健康問題並給予適當處理。

63歲老人骨質疏鬆可以透過一般治療、藥物治療等方式進行改善,能夠有效緩解症狀。

老人骨質疏鬆症的治療主要包括一般治療、藥物治療和手術治療,建議老人及時就醫,在醫生指導下進行針對性治療。

老人骨質疏鬆打針有用,但具體效果因人而異。老人骨質疏鬆主要是由於年齡增長、荷爾蒙下降等因素導致的骨骼代謝異常,從而引起骨量減少、骨組織微結構破壞等病理改變。

老人骨質疏鬆打針的利弊,主要包括促進骨骼形成、增加骨密度、降低骨折風險等。但需要在醫生指導下進行治療,避免自行用藥。

90歲老人骨質疏鬆能活多久這種說法不準確,因為每個人的體質不同,所以無法判斷具體時間。骨質疏鬆可能是由於年齡增長、內分泌因素等原因引起的,患者需要根據病因進行針對性治療。